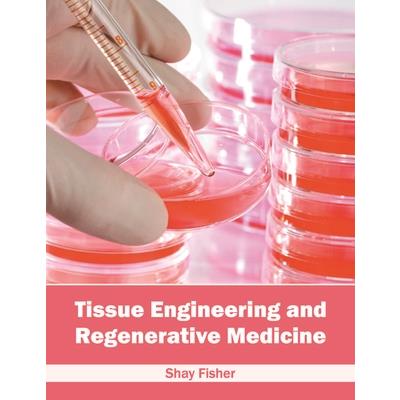

Tissue Engineering and Regenerative Medicine
Tissue Engineering and Regenerative Medicine
-
9折 5349元
5943元
-
 預計最高可得金幣265點
?
可100%折抵
預計最高可得金幣265點
?
可100%折抵
活動加倍另計 -
HAPPY GO享100累1點 4點抵1元 折抵無上限
-
分類:英文書>健康生活>醫療保健>醫療科技/研究追蹤? 追蹤分類後,您會在第一時間收到分類新品通知。
- 作者: Shay,Fisher 追蹤 ? 追蹤作者後,您會在第一時間收到作者新書通知。
- 出版社: Hayle Medical 追蹤 ? 追蹤出版社後,您會在第一時間收到出版社新書通知。
- 出版日:2021/10/22
內容簡介
Tissue engineering is a branch of medicine that is majorly dependent on biomaterials. It combines material methods, cells, and biologically active molecules to form functionally active tissues. Regenerative medicine is a branch of tissue engineering which is based on the concept of self-healing with the help of some biological materials to rebuild and recreate tissues and organs. This book provides significant information of this discipline to help develop a good understanding of the core concepts and related aspects of these subjects. As these fields are emerging at a rapid pace, the contents of this book will help the readers get a better understanding of the modern concepts and applications of these subjects.
配送方式
-
台灣
- 國內宅配:本島、離島
-
到店取貨:
-
海外
- 國際快遞:全球
訂購/退換貨須知
加入金石堂 LINE 官方帳號『完成綁定』,隨時掌握出貨動態:
商品運送說明:
- 本公司所提供的產品配送區域範圍目前僅限台灣本島。注意!收件地址請勿為郵政信箱。
- 商品將由廠商透過貨運或是郵局寄送。消費者訂購之商品若無法送達,經電話或 E-mail無法聯繫逾三天者,本公司將取消該筆訂單,並且全額退款。
- 當廠商出貨後,您會收到E-mail出貨通知,您也可透過【訂單查詢】確認出貨情況。
- 產品顏色可能會因網頁呈現與拍攝關係產生色差,圖片僅供參考,商品依實際供貨樣式為準。
- 如果是大型商品(如:傢俱、床墊、家電、運動器材等)及需安裝商品,請依商品頁面說明為主。訂單完成收款確認後,出貨廠商將會和您聯繫確認相關配送等細節。
- 偏遠地區、樓層費及其它加價費用,皆由廠商於約定配送時一併告知,廠商將保留出貨與否的權利。
提醒您!!
金石堂及銀行均不會請您操作ATM! 如接獲電話要求您前往ATM提款機,請不要聽從指示,以免受騙上當!
退換貨須知:
**提醒您,鑑賞期不等於試用期,退回商品須為全新狀態**
-
依據「消費者保護法」第19條及行政院消費者保護處公告之「通訊交易解除權合理例外情事適用準則」,以下商品購買後,除商品本身有瑕疵外,將不提供7天的猶豫期:
- 易於腐敗、保存期限較短或解約時即將逾期。(如:生鮮食品)
- 依消費者要求所為之客製化給付。(客製化商品)
- 報紙、期刊或雜誌。(含MOOK、外文雜誌)
- 經消費者拆封之影音商品或電腦軟體。
- 非以有形媒介提供之數位內容或一經提供即為完成之線上服務,經消費者事先同意始提供。(如:電子書、電子雜誌、下載版軟體、虛擬商品…等)
- 已拆封之個人衛生用品。(如:內衣褲、刮鬍刀、除毛刀…等)
- 若非上列種類商品,均享有到貨7天的猶豫期(含例假日)。
- 辦理退換貨時,商品(組合商品恕無法接受單獨退貨)必須是您收到商品時的原始狀態(包含商品本體、配件、贈品、保證書、所有附隨資料文件及原廠內外包裝…等),請勿直接使用原廠包裝寄送,或於原廠包裝上黏貼紙張或書寫文字。
- 退回商品若無法回復原狀,將請您負擔回復原狀所需費用,嚴重時將影響您的退貨權益。

商品評價